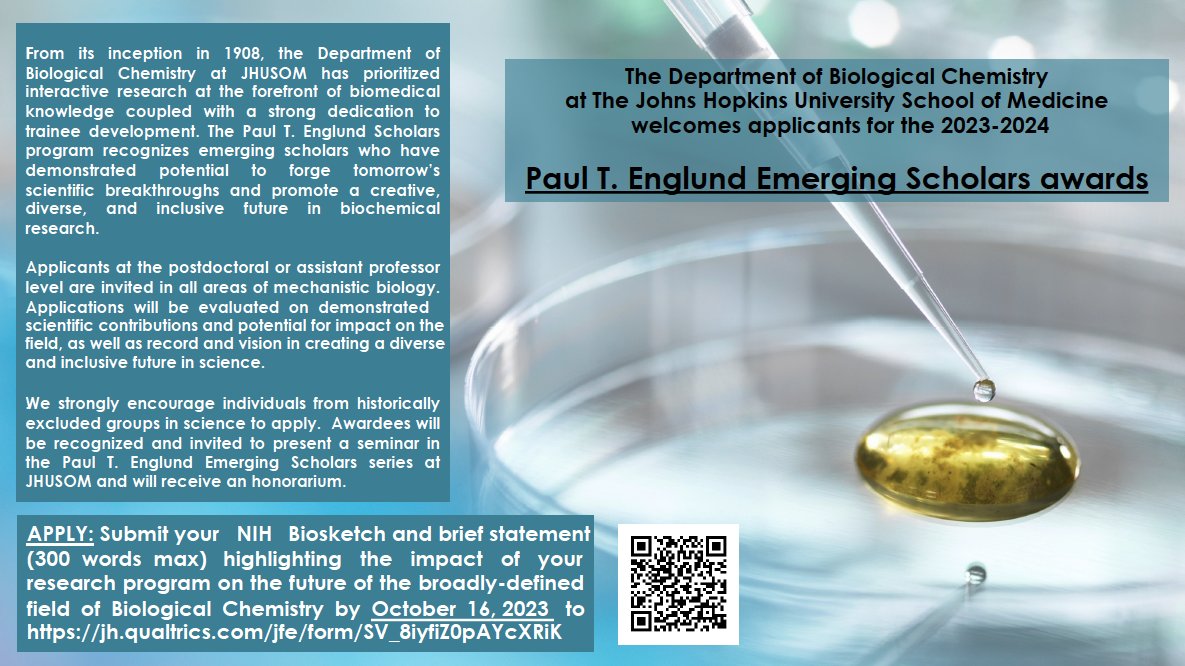
Upcoming application deadline for the 2023-2024 Paul T. Englund Emerging Scholars Award, which received an INSIGHT Into Diversity ‘Inspiring Programs in STEM’ award in 2023 (biolchem.bs.jhmi.edu/englund-emergi…).

Applicants at the postdoctoral or assistant professor level are invited in all

mollie meffert
@mmeffert
ID: 28220928
01-04-2009 23:04:57
12 Tweet
19 Takipçi
37 Takip Edilen



Biological Chemistry at Johns Hopkins is accepting applications for the inaugural Paul T. Englund Emerging Scholars Awards. CV & statement of impact due 10/15/22 (email to: [email protected]). Individuals from historically excluded groups in science are strongly encouraged to apply!



USASP member newsletter is in your email today! Check it out for great content, including getting to know our Twitter Team lead: Xinbei Li is a PhD candidate at Johns Hopkins University Her research is on unraveling the intricate post-transcriptional mechanisms underlying neuropathic pain


Congratulations to scientist Bonita Powell, a third-year BCMB Graduate Program at JHMI student, who has been named one of HHMI's #GilliamFellows. @HHMINews Photo: (right, Bonita Powell; left, faculty mentor Mollie Meffert)





The BC Dept and IBBS Johns Hopkins Medicine are proud to announce this year's Paul T. Englund Emerging Scholars. Each awardee will present a seminar this spring. Congrats to Willow Coyote-Maestas Silva Lab at Duke - @thesilvalab.bsky.social Lisa Eshun-Wilson Eric Villalon Landeros, PhD @PravruthaRaman 🧬Jacob L Steenwyk 🤩